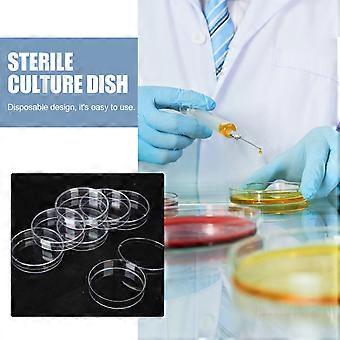
product image

Transparent Plastic Petri Dishes with Lids for Storage and Experiments 30pcs
la livraison GRATUITE

Transparent Plastic Petri Dishes with Lids for Storage and Experiments 30pcs
- Marque: Unbranded
Transparent Plastic Petri Dishes with Lids for Storage and Experiments 30pcs
- Marque: Unbranded
Économisez 14.00 CHF (40%)
Prix de vente recommandé
Politique de retour sur 14 jours
Économisez 14.00 CHF (40%)
Prix de vente recommandé
Politique de retour sur 14 jours
Modes de paiement:
Description
Transparent Plastic Petri Dishes with Lids for Storage and Experiments 30pcs
- Marque: Unbranded
- Catégorie: Boîtes de Petri
- Identifiant Fruugo: 449604193-946195437
- EAN: 3382234733464
Informations sur la sécurité des produits
Veuillez consulter les informations de sécurité du produit spécifiques à ce produit décrites ci-dessous.
Les informations suivantes sont fournies par le détaillant tiers indépendant vendant ce produit.
Étiquettes de sécurité des produits

Livraison & retours
Expédition dans un délai de 2 jours
-
STANDARD: GRATUIT - Livraison entre lun. 12 janvier 2026–lun. 19 janvier 2026 - GRATUIT
Expédition de Chine.
Nous mettons tout en œuvre pour que les produits que vous commandez vous soient livrés dans leur intégralité et selon vos indications. Néanmoins, si vous recevez une commande incomplète, des articles différents de ceux commandés ou si, pour toute autre raison, la commande ne vous satisfait pas, vous pouvez retourner la commande ou tout produit inclus dans celle-ci et recevoir un remboursement complet des articles. Voir l'intégralité de la politique de retour
Détails de conformité du produit
Veuillez consulter les informations de conformité spécifiques à ce produit décrites ci-dessous.
Les informations suivantes sont fournies par le détaillant tiers indépendant vendant ce produit.
Fabricant:
Les informations suivantes indiquent les coordonnées du fabricant du produit concerné vendu sur Fruugo.
- Shenzhen Woyingpei Trade Co., Ltd.
- Shenzhen Woyingpei Trade Co., Ltd.
- shen zhen shi nan shan qu yue hai jie dao ke ji yuan she qu ke zhi xi lu 1 hao ke yuan xi 23 dong bei 2101
- Shenzhen
- CN
- 518000
- mnvasfafaa@hotmail.com
- 19925352422
Personne responsable dans l'UE:
Les informations suivantes indiquent les coordonnées de la personne responsable dans l'UE. La personne responsable est l'opérateur économique désigné basé dans l'UE qui est responsable des obligations de conformité relatives au produit concerné vendu dans l'Union européenne.
- EC REP SERVICES SL
- EC REP SERVICES SL
- Calle Gran Via 49, 7 Dch.
- Madrid
- ES
- 28013
- ecrepservice@hotmail.com
- 0034 910 5631 02